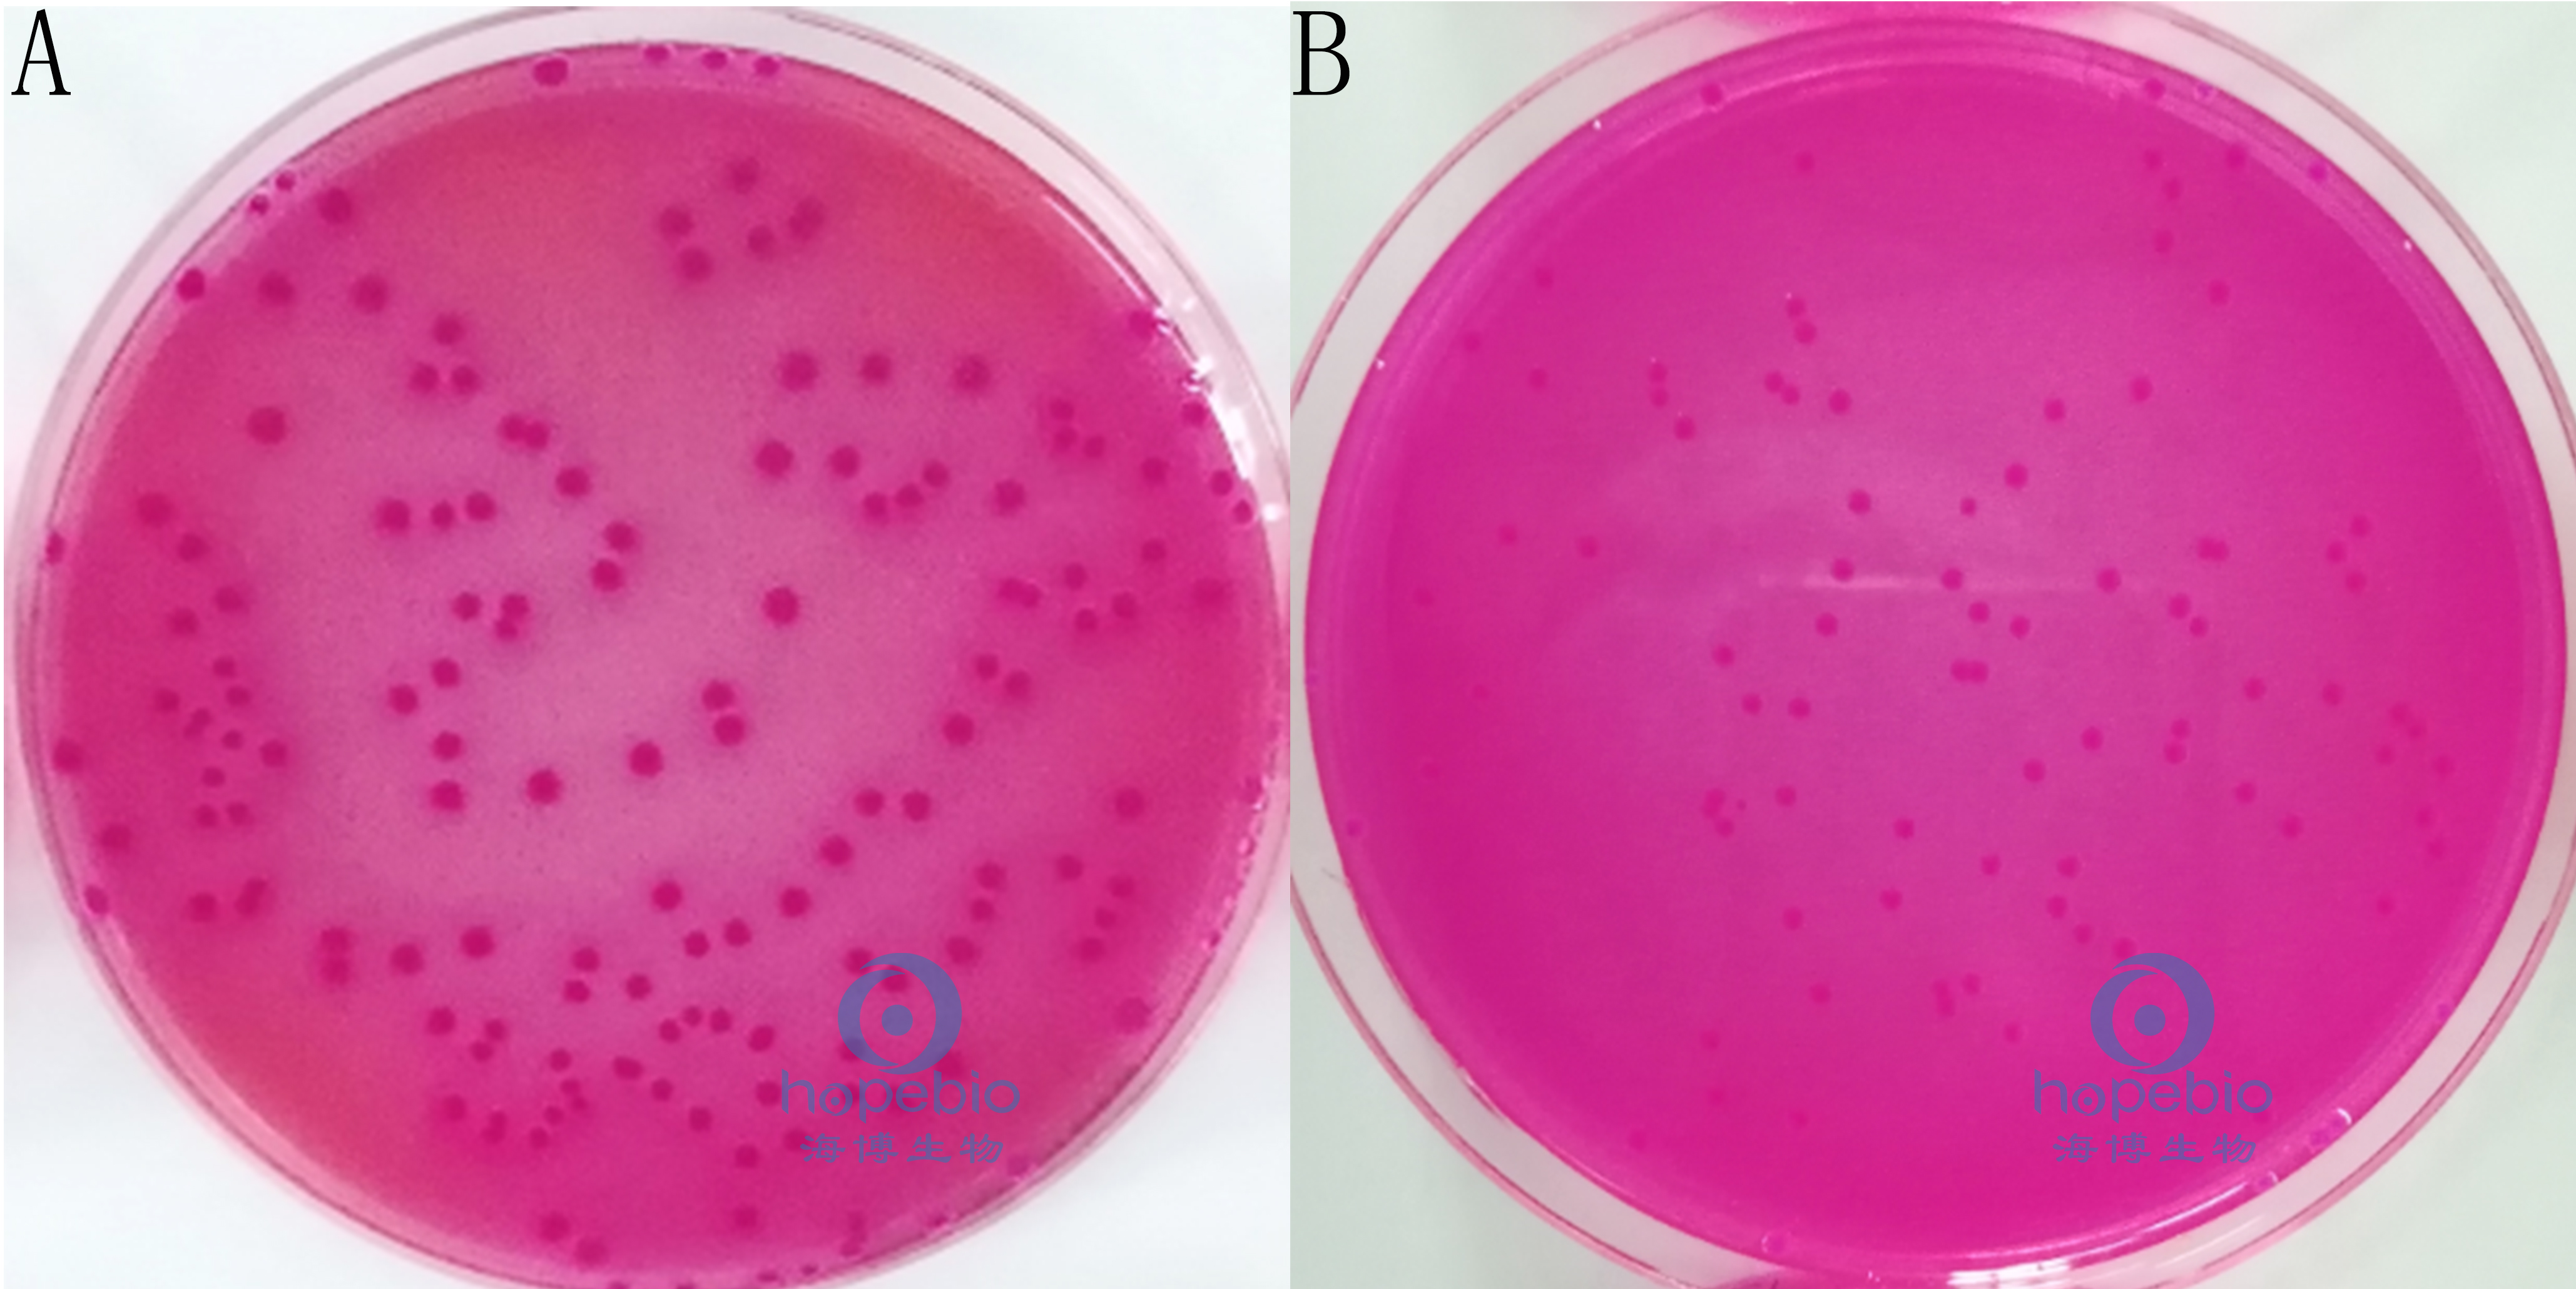

海博微信公众号
海博微信公众号
 海博天猫旗舰店
海博天猫旗舰店


 海博微信公众号
海博微信公众号
 海博天猫旗舰店
海博天猫旗舰店




一、简介
小肠结肠炎耶尔森氏菌(Yersinia enterocolitica),简称小肠耶尔森氏菌,是革兰氏阴性杆菌或球杆菌,大小为1-3.5×0.5-1.3μm,多单个散在,有时排列成短链或成堆。本菌不形成芽胞,无荚膜,有周鞭毛;但其鞭毛在30℃以下培养条件形成,温度较高时即丧失,因此表现为30℃以下有动力,而35℃以上则无动力。该菌是能在冷藏温度下生长的少数几种肠道致病菌之一,在4℃条件下能保存和繁殖。小肠耶尔森氏菌在自然界分布很广。
二、参考标准
《GB 4789.8-2016 食品安全国家标准 小肠结肠炎耶尔森氏菌检验》
三、检验方法以及结果分析
1.分离
将样品进行梯度稀释后,选择合适的稀释度涂布CIN-1琼脂平板和改良Y 琼脂平板,26℃±1℃培养48h±2h。
小肠耶尔森氏菌典型菌落在CIN-1上为深红色中心,周围具有无色透明圈(红色牛眼状菌落),菌落大小为1mm~2mm,在改良Y琼脂平板上为无色透明、不黏稠的菌落。如图1所示:
A:CIN-1琼脂平板;B:改良Y琼脂平板
图1
2.改良克氏双糖试验
分别挑取CIN-1琼脂平板和改良Y琼脂平板的可疑菌落3个~5个,分别接种于改良克氏双糖铁琼脂,接种时先在斜面划线,再于底层穿刺,26℃±1℃培养24h,将斜面和底部皆变黄且不产气的培养物做进一步的生化鉴定。如图2所示:

小肠耶尔森氏菌改良克氏双糖试验结果
图2
3.尿素酶试验和动力观察
用接种环挑取可疑培养物,接种到尿素培养基中,26℃±1℃培养2h~4h。将尿素酶试验阳性菌落分别接种于两管半固体培养基中,于26℃±1℃和36℃±1℃培养24h。将在26℃有动力而36℃无动力的可疑菌培养物划线接种营养琼脂平板,进行纯化培养,用纯化物进行革兰氏染色镜检和生化试验。
小肠耶尔森氏菌尿素酶试验阳性,培养基变为玫红色,如图3所示:

左:空白对照;右:小肠耶尔森氏菌
图3
小肠耶尔森氏菌穿刺接种于半固体琼脂中,在26℃培养有动力而在36℃培养无动力,如图4所示:

A:空白对照;B:小肠耶尔森氏菌
图4
4.生化鉴定
从营养琼脂平板上挑取单个菌落接种生化反应管,生化反应在26℃±1℃进行。小肠耶尔森氏氏菌的主要生化特征以及与其他相似菌的区别见表1。
表1 小肠耶尔森氏氏菌与其他相似菌的生化性状鉴别表
|
项目 |
小肠耶尔森氏氏菌 |
中间型耶尔森氏菌 |
弗氏耶尔森氏菌 |
克氏耶尔森氏菌 |
假结核耶尔森氏菌 |
鼠疫耶尔森氏菌 |
|
动力(26℃) |
+ |
+ |
+ |
+ |
+ |
- |
|
尿素酶 |
+ |
+ |
+ |
+ |
+ |
- |
|
V-P试验(26℃) |
+ |
+ |
+ |
- |
- |
- |
|
鸟氨酸脱羧酶 |
+ |
+ |
+ |
+ |
- |
- |
|
蔗糖 |
d |
+ |
+ |
- |
- |
- |
|
棉子糖 |
- |
+ |
- |
- |
- |
d |
|
山梨醇 |
+ |
+ |
+ |
+ |
- |
- |
|
甘露醇 |
+ |
+ |
+ |
+ |
+ |
+ |
|
鼠李糖 |
- |
+ |
+ |
- |
- |
+ |
|
注:+阳性;-阴性;d有不同生化型。 |
||||||
使用海博生化管进行生化鉴定,小肠耶尔森氏菌生化反应结果为鸟氨酸脱羧酶阳性、蔗糖阳性、棉子糖阴性、山梨醇阳性、甘露醇阳性、鼠李糖阴性和V-P试验阳性(26℃)。如图5所示:

A:空白对照;B:小肠耶尔森氏菌
图5
注:本文属海博生物原创,未经允许不得转载。
下一篇:食品中志贺氏菌检验简单介绍(上)



